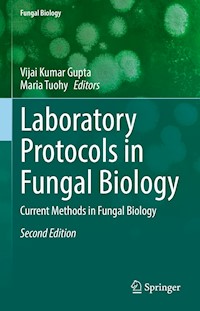
Laboratory Protocols in Fungal Biology -  - E-Book

171,19 €
Mycology has an integral role to play in the development of the biotechnology and biomedical sectors. It has become a subject of increasing importance as new fungi and their associated biomolecules are identified. As this discipline comes to the forefront of research in these sectors, the requirement for a consolidation of available research approaches is required. The First Edition of this book has a few basic and applied protocols. With the Second Edition, this book provides consolidated information on recent developments and the most widely used mycological methods available in the fields of biochemistry, biotechnology and microbiology. The methods outlined offer clear and concise directions to the reader and covers both standard protocols and more applied mycological methods. This book provides useful information for undergraduates, post-graduates, and specialists and researchers studying fungal biology.
Das E-Book können Sie in einer beliebigen App lesen, die das folgende Format unterstützt:
Veröffentlichungsjahr: 2022